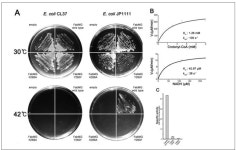
[보고서]농작물 병원성을 유발하는 식물병원균 이펙터들의 기능 규명

농업 유용미생물 배양센터(옥내)3 총61명이 열람하였으며, 0개의 리뷰가 있습니다.
- 번호
- 55,217
- 설치장소명
- 농업 유용미생물 배양센터(옥내)3
- 설치장소상세
- 농업기술센터
- 설치시도명
- 전라남도
- 설치시군구명
- 보성군
- 설치시설구분
- 지역문화시설
- 서비스제공사명
- KT
- 와이파이SSID
- Boseong@FREEWIFi
- 설치연월
- 2020-12
- 소재지도로명주소
- 전라남도 보성군 보성읍 녹차로 1347-16
- 소재지지번주소
- 전라남도 보성군 보성읍 옥평리 746
- 관리기관명
- 보성군
- 관리기관전화번호
- 061-850-5145
- WGS84위도
- 35
- WGS84경도
- 127
- 데이터기준일자
- 2023-03-10
주변 목록
농업 유용미생물 배양센터(옥내)
전라남도 보성군 보성읍 녹차로 1347-16
'농업 유용미생물 배양센터(옥내)3'에서 0km
농업기술센터
바로가기
농업 유용미생물 배양센터(옥내)2
전라남도 보성군 보성읍 녹차로 1347-16
'농업 유용미생물 배양센터(옥내)3'에서 0km
농업기술센터
바로가기
농업기술센터
전라남도 보성군 보성읍 녹차로 1357
'농업 유용미생물 배양센터(옥내)3'에서 0.2km
청사내부
바로가기
농업기술센터첨단농업관
전라남도 보성군 보성읍 녹차로 1357
'농업 유용미생물 배양센터(옥내)3'에서 0.2km
청년농업인활동실,협의실,교육관
바로가기
농업기술센터
전라남도 보성군 보성읍 녹차로 1357
'농업 유용미생물 배양센터(옥내)3'에서 0.2km
청사내부
바로가기
다향고정류장(옥외)
전라남도 보성군 보성읍 녹차로 1367
'농업 유용미생물 배양센터(옥내)3'에서 0.4km
버스정류장
바로가기
보성읍 우춘경로당
전라남도 보성군 보성읍 중앙로 7
'농업 유용미생물 배양센터(옥내)3'에서 0.7km
경로당 내부
바로가기
보성읍 장미경로당
전라남도 보성군 보성읍 중앙로 30-40
'농업 유용미생물 배양센터(옥내)3'에서 0.8km
경로당 내부
바로가기
주변 공중 화장실
동윤천생태공원 화장실
전라남도 보성군 보성읍 보성리 44
'농업 유용미생물 배양센터(옥내)3'에서 1km
바로가기
보성농협주유소
전라남도 보성군 보성읍 중앙로 55
'농업 유용미생물 배양센터(옥내)3'에서 1.03km
바로가기
녹차골 금강휴게소 화장실
전라남도 보성군 보성읍 녹색로 2843
'농업 유용미생물 배양센터(옥내)3'에서 1.06km
바로가기
제일에너지(주) 녹차골엘피지충전소
전라남도 보성군 보성읍 녹색로 2828
'농업 유용미생물 배양센터(옥내)3'에서 1.08km
바로가기
녹차골휴게소화장실
전라남도 보성군 보성읍 녹색로 2836
'농업 유용미생물 배양센터(옥내)3'에서 1.13km
바로가기
제일에너지㈜ 녹차골주유소
전라남도 보성군 보성읍 녹색로 2846
'농업 유용미생물 배양센터(옥내)3'에서 1.15km
바로가기
보성역
전라남도 보성군 보성읍 현충로 90
'농업 유용미생물 배양센터(옥내)3'에서 1.15km
바로가기
보성명가
전라남도 보성군 보성읍 용문길 7
'농업 유용미생물 배양센터(옥내)3'에서 1.24km
바로가기
봇재제2주유소
전라남도 보성군 보성읍 용문길 13
'농업 유용미생물 배양센터(옥내)3'에서 1.28km
바로가기
매일시장화장실1
전라남도 보성군 보성읍 신흥길 9
'농업 유용미생물 배양센터(옥내)3'에서 1.3km
바로가기
매일시장화장실2
전라남도 보성군 보성읍 신흥길 9
'농업 유용미생물 배양센터(옥내)3'에서 1.3km
바로가기
보성읍행정복지센터 2층 화장실
전라남도 보성군 신흥길 17
'농업 유용미생물 배양센터(옥내)3'에서 1.35km
바로가기
주변 그늘막 쉼터
해남군 보건소 앞
전라남도 해남군 해남읍 해남로 46
'농업 유용미생물 배양센터(옥내)3'에서 48.68km
바로가기
해남종합터미널 맞은편(건강약국 앞)
'농업 유용미생물 배양센터(옥내)3'에서 49.03km
바로가기
택시부 그늘막(해남종합터미널 옆)
'농업 유용미생물 배양센터(옥내)3'에서 49.17km
바로가기
해남동초등학교 사거리(엠비엠문구사 앞)
'농업 유용미생물 배양센터(옥내)3'에서 49.31km
바로가기
해남동초등학교 사거리(엠비엠문구사 옆)
'농업 유용미생물 배양센터(옥내)3'에서 49.31km
바로가기
해남동초등학교 정문
전라남도 해남군 해남읍 동초길 59-15
'농업 유용미생물 배양센터(옥내)3'에서 49.32km
바로가기
해남동초등학교 사거리(초등학교 방향)
전라남도 해남군 해남읍 동초길 59-15
'농업 유용미생물 배양센터(옥내)3'에서 49.32km
바로가기
해남동초등학교 사거리(해남우체국 옆)
'농업 유용미생물 배양센터(옥내)3'에서 49.34km
바로가기
해남문화원 사거리
'농업 유용미생물 배양센터(옥내)3'에서 49.49km
바로가기
해남군청 사거리
'농업 유용미생물 배양센터(옥내)3'에서 49.49km
바로가기
(구)국민은행 앞
전라남도 해남군 해남읍 중앙1로 99
'농업 유용미생물 배양센터(옥내)3'에서 49.5km
바로가기
농협 해남군지부 앞
전라남도 해남군 해남읍 중앙1로 147
'농업 유용미생물 배양센터(옥내)3'에서 49.68km
바로가기
주변 세탁소 빨래방
운동화&이불빠는날
전라남도 보성군 보성읍 보성리 96-2
'농업 유용미생물 배양센터(옥내)3'에서 1.14km
바로가기
선일 컴퓨터 세탁소
전라남도 보성군 보성읍 보성리 891-17번지
'농업 유용미생물 배양센터(옥내)3'에서 1.19km
바로가기
창신
전라남도 보성군 보성읍 보성리 826-1번지
'농업 유용미생물 배양센터(옥내)3'에서 1.23km
바로가기
광주
전라남도 보성군 보성읍 보성리 894-9번지
'농업 유용미생물 배양센터(옥내)3'에서 1.25km
바로가기
개운세탁소
전라남도 보성군 보성읍 보성리 836-2번지
'농업 유용미생물 배양센터(옥내)3'에서 1.39km
바로가기
진보세탁소
전라남도 보성군 득량면 예당리 430-9번지
'농업 유용미생물 배양센터(옥내)3'에서 10.28km
바로가기
청광프라자
전라남도 보성군 조성면 조성리 650-64
'농업 유용미생물 배양센터(옥내)3'에서 15.21km
바로가기
주식회사 월광크린산업
전라남도 보성군 복내면 복내리 435-11
'농업 유용미생물 배양센터(옥내)3'에서 15.25km
바로가기
드라이 하우스
전라남도 장흥군 장흥읍 건산리 390번지
'농업 유용미생물 배양센터(옥내)3'에서 19.02km
바로가기
전남세탁소
전라남도 장흥군 장흥읍 건산리 721-30번지
'농업 유용미생물 배양센터(옥내)3'에서 19.04km
바로가기
갑용세탁소
전라남도 장흥군 장흥읍 예양리 32-4번지
'농업 유용미생물 배양센터(옥내)3'에서 19.66km
바로가기
학동세탁소
전라남도 고흥군 도덕면 도덕리 52-3번지
'농업 유용미생물 배양센터(옥내)3'에서 22.95km
바로가기
주변 약수터
봉화천
'농업 유용미생물 배양센터(옥내)3'에서 0.95km
바로가기
평화약수터
전라남도 장흥군 장흥읍 평화리 40-1
'농업 유용미생물 배양센터(옥내)3'에서 18.97km
바로가기
억불샘약수터
전라남도 장흥군 장흥읍 평화리 산10-2
'농업 유용미생물 배양센터(옥내)3'에서 19.06km
바로가기
사또샘약수터
전라남도 장흥군 장흥읍 동동리 55-1
'농업 유용미생물 배양센터(옥내)3'에서 19.93km
바로가기
한천 참샘
전라남도 화순군 한천면 한계리 산 74-1
'농업 유용미생물 배양센터(옥내)3'에서 26.6km
바로가기
기알재
전라남도 강진군 병영면 한학리 산239
'농업 유용미생물 배양센터(옥내)3'에서 26.88km
바로가기
송광사
전라남도 순천시 송광면 송광사안길 100
'농업 유용미생물 배양센터(옥내)3'에서 31.69km
바로가기
보은산
전라남도 강진군 강진읍 남성리 산3
'농업 유용미생물 배양센터(옥내)3'에서 32.09km
바로가기
탑골
전라남도 강진군 강진읍 남성리 108-1
'농업 유용미생물 배양센터(옥내)3'에서 32.45km
바로가기
냉천약수터
전라남도 영암군 금정면 연보리 587-2
'농업 유용미생물 배양센터(옥내)3'에서 32.5km
바로가기
낙하정
전라남도 강진군 강진읍 서성리 79-1
'농업 유용미생물 배양센터(옥내)3'에서 33.07km
바로가기
동복 땀띠샘
전라남도 화순군 동복면 독상리 산 32
'농업 유용미생물 배양센터(옥내)3'에서 33.91km
바로가기
주변 도시 공원
보성3소공원
'농업 유용미생물 배양센터(옥내)3'에서 1.47km
바로가기
판소리테마파크
'농업 유용미생물 배양센터(옥내)3'에서 9.15km
바로가기
동율소공원
'농업 유용미생물 배양센터(옥내)3'에서 9.67km
바로가기
동곡소공원
'농업 유용미생물 배양센터(옥내)3'에서 10.57km
바로가기
비봉근린공원
'농업 유용미생물 배양센터(옥내)3'에서 11.07km
바로가기
예당생태 근린공원
'농업 유용미생물 배양센터(옥내)3'에서 11.97km
바로가기
숨쉼터
전라남도 장흥군 안양면 로하스로 157
'농업 유용미생물 배양센터(옥내)3'에서 15.03km
바로가기
약초테마공원
전라남도 장흥군 안양면 로하스로 157
'농업 유용미생물 배양센터(옥내)3'에서 15.03km
바로가기
조성농동단지공원
'농업 유용미생물 배양센터(옥내)3'에서 15.44km
바로가기
장평제2농공단지
전라남도 장흥군 장평면 농공단지길 46-29
'농업 유용미생물 배양센터(옥내)3'에서 15.47km
바로가기
수변노을공원
'농업 유용미생물 배양센터(옥내)3'에서 16.25km
바로가기
바이오산단 체육공원
전라남도 장흥군 장흥읍 산단1로 76-16
'농업 유용미생물 배양센터(옥내)3'에서 16.55km
바로가기
블로그 리뷰
-
외 유용 천연물 소재 표본 등 소개 천연물클러스터_한국생명공학연구원 해외생물소재센터 <합성화합물 클러스터> · 단백질과 화합물 결합에 대한 VR 체험...보유한 종자 소개 종자클러스터 중앙은행_농업유전자원센터 <미생물 클러스터(생물자원센터)> · 상황버섯 균사체의 배양 시연 · 배양체로 만든 인조가죽 소개...
KOBIC 바이오소재 총괄지원단(2025-12-31 10:00:00)

-
사용 후기를 전해 드리려 해요. 그리고 교육받으면서 스쳐 지나가기만 했던, 센터 안에 있는 민들레 희망 가게도 함께 추천해 보려 합니다. 사실 EM 치약과 비누는 이번에 처음 사용해 봤는데요, 직접 써보니 생각보다 훨씬 좋아서 "이 제품, 혹시 희망 가게에서 파는 건가?" 하는 관심이 생겼어요. 그래서 다시 민들레...
Always,늘on(2025-07-24 06:00:00)

-
효과를 볼 수 있습니다. Q3: 미생물 비료를 가장 저렴하게 구하는 방법은 없나요? A: 각 지역의 '농업기술센터'를 활용하는 것이 가장 좋은 방법입니다. 대부분의 시군 농업기술센터에서는 농민들을 위해 유용미생물(EM)을 직접 배양하여 매우 저렴한 가격(예: 리터당 300~400원)에 공급하고 있습니다. 거주지 농업...
농부는모른다(2025-07-01 15:00:15)

-
다른 유용 미생물의 증식을 돕고 작물의 면역력을 높여줍니다. 트리코더마(Trichoderma)균: 토양 속 곰팡이 병원균에 대한 길항 작용이 매우 뛰어나 잘록병...필자의 경험에 따르면, 처음 미생물비료를 사용한다면 여러 유익균이 복합적으로 배양된 '복합 미생물제제'를 사용하는 것이 다양한 효과를 동시에 볼 수...
농부랑 보따리(2025-09-18 13:50:00)

-
종류: 농업기술센터에서 배양하는 유용 미생물(EM, 광합성균, 고초균, 유산균 등), 시판 미생물 제제(바실러스, 트리코더마 등) 등 다양합니다. 활용법: 물에 희석하여 관주하거나 엽면시비합니다. 토양에 살포하여 토양 미생물 환경을 개선하거나, 작물 면역력을 높이는 데 사용됩니다. "매주 미생물 관주하니 확실히...
토경 마스터 솔루션(2025-06-17 00:25:00)

-
70억 인구의 식량과 의약품 공급, 환경오염 물질로 더럽힌 대기와 물 정화, 토양의 비옥도 유지, 대기의 기후 조건 유지 등이 이에 해당한다. 최근 유용 미생물을 이용한 생명공학 산업이 발달하면서 산업 미생물도 지원해야 한다는 요청이 날로 증가하고 있다. 특히 표준화된 발효 미생물을 확보하고 보존하는 업무...
농업인과의 동행[010 5464 1181](2024-12-27 08:00:00)

-
확인하고, 후기가 좋은 제품을 선택합니다. 가격이 조금 비싸더라도 안전한 제품을 사용하는 것이 중요하다고 생각합니다. 농도 높다고 다 좋은 건 아니에요! 목초액 은 농도가 높을수록 효과가 좋다고 생각하는 분들이 있는데, 절대 그렇지 않습니다! 오히려 피부나 식물에 자극을 줄 수 있고, 부작용을 일으킬 가능성...
건강정보일기장(2025-08-09 04:07:20)

-
지난 3일부터 5일까지 일정으로 도를 방문한 중국 강소성 생태환경청 방문단과의 환경행정교류회를 성공적으로 마무리했다고 밝혔다. 도와 강소성은 2004년 ‘환경행정교류협약’을 체결한 이후 현재까지 36차례의 교류를 이어오며 동북아 주요 환경 현안 해결을 위한 협력 기반을 다져왔다. 이번 교류회는 지난 5...
정보와 사람을 잇다, 당진교차로(2025-09-05 17:12:00)

-
미생물들을 배양하여 만든 액체 상태이기 때문에, 우리 생활 곳곳에 간편하게 활용할 수 있다는 장점이 있어요. ✨ EM 발효액, 이런 점이 좋아요! 악취 제거 : 집...방지 효과를 얻을 수 있고, 더욱 쾌적한 환경을 만들 수 있습니다. 농업 활용 : 텃밭이나 화분에 EM 발효액을 사용하면 작물 생육을 촉진하고, 건강한 흙...
policycash(2025-05-21 20:50:35)

-
작용으로 < #유용미생물 증식 환경>을 조성하고, 흡수되기 쉬운 < #영양소, 각종 미네랄>을 다량 함유한 <물>을 의미한다. 이는 <작물 생육 증진, 축사 악취...지역 농업인 미생물 보급 활성화>를 위해 ' #남부농기계임대사업소'에 < #배양시설 추가설치>해 소외될 수 있는 지역 농업인들에게도 <혜택>을 제공할 예정...
aeran0704(2024-08-18 23:44:00)

일별 방문 통계
월별 방문 통계
날씨
리뷰 (0)
등록된 리뷰가 없습니다.
첨부파일
![네이버 인플루언서 [네이버 인플루언서] 농사를 잘 배우는 방법과 미생물 배양하면 안되는 이유 feat. 농사의여신 시범포 방문 3탄](https://search.pstatic.net/sunny/?type=b150&src=https%3A%2F%2Fi.ytimg.com%2Fvi%2FG_IIpBVXZ5M%2Fmaxresdefault.jpg)













![[명인의 작물관리법] 종균 배양실 위생관리 철저…오염률 낮추고 생산비 절감](https://search.pstatic.net/common/?type=b150&src=http%3A%2F%2Fimgnews.naver.net%2Fimage%2F5084%2F2021%2F09%2F10%2F0000164159_001_20210910002005967.jpg)

![[보고서]농작물 병원성을 유발하는 식물병원균 이펙터들의 기능 규명](https://search.pstatic.net/sunny/?type=b150&src=https%3A%2F%2Fnrms.kisti.re.kr%2Fbitextimages%2FTRKO202100000544%2FTRKO202100000544_9_image_14.png)
![[보고서]농작물 병원성을 유발하는 식물병원균 이펙터들의 기능 규명](https://search.pstatic.net/sunny/?type=b150&src=https%3A%2F%2Fnrms.kisti.re.kr%2Fbitextimages%2FTRKO202100000544%2FTRKO202100000544_16_image_1.png)
![[보고서]농작물 병원성을 유발하는 식물병원균 이펙터들의 기능 규명](https://search.pstatic.net/sunny/?type=b150&src=https%3A%2F%2Fnrms.kisti.re.kr%2Fbitextimages%2FTRKO202100000544%2FTRKO202100000544_15_image_1.png)
![[보고서]농작물 병원성을 유발하는 식물병원균 이펙터들의 기능 규명](https://search.pstatic.net/sunny/?type=b150&src=https%3A%2F%2Fnrms.kisti.re.kr%2Fbitextimages%2FTRKO202100000544%2FTRKO202100000544_12_image_1.png)
![[보고서]농작물 병원성을 유발하는 식물병원균 이펙터들의 기능 규명](https://search.pstatic.net/sunny/?type=b150&src=https%3A%2F%2Fnrms.kisti.re.kr%2Fbitextimages%2FTRKO202100000544%2FTRKO202100000544_13_image_1.png)
![[보고서]농작물 병원성을 유발하는 식물병원균 이펙터들의 기능 규명](https://search.pstatic.net/sunny/?type=b150&src=https%3A%2F%2Fnrms.kisti.re.kr%2Fbitextimages%2FTRKO202100000544%2FTRKO202100000544_15_image_2.png)
![[보고서]농작물 병원성을 유발하는 식물병원균 이펙터들의 기능 규명](https://search.pstatic.net/sunny/?type=b150&src=https%3A%2F%2Fnrms.kisti.re.kr%2Fbitextimages%2FTRKO202100000544%2FTRKO202100000544_10_image_1.png)
![[이상엽의 공학이야기] 미생물 식품](https://search.pstatic.net/common/?type=b150&src=http%3A%2F%2Fimgnews.naver.net%2Fimage%2F032%2F2021%2F08%2F26%2F0003094160_001_20250525065738011.jpg)
![농업 유용미생물 배양센터(옥내)3 | [공지] EM 치약·비누추천 솔직 사용 후기, 천안 YWCA 친환경 제품&먹거리 운동|중년서포터즈#6](https://search4.kakaocdn.net/argon/130x130_85_c/5fFoSRNgVO)





